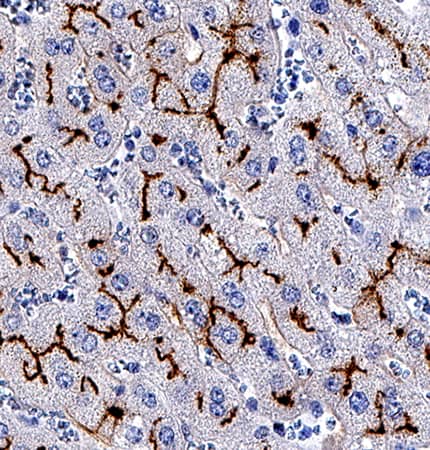
Aminopeptidase N/CD13 antibody in Human Liver by Immunohistochemistry (IHC-P).

Human Aminopeptidase N/CD13 Antibody
R&D Systems, part of Bio-Techne | Catalog # MAB38152


Key Product Details
Species Reactivity
Applications
Label
Antibody Source
Product Specifications
Immunogen
Lys69-Lys967
Accession # AAA51719
Specificity
Clonality
Host
Isotype
Scientific Data Images for Human Aminopeptidase N/CD13 Antibody
Detection of Aminopeptidase N/CD13 in U937 Human Cell Line by Flow Cytometry.
U937 human histiocytic lymphoma cell line was stained with Mouse Anti-Human Aminopeptidase N/CD13 Monoclonal Antibody (Catalog # MAB38152, filled histogram) or isotype control antibody (Catalog # MAB003, open histogram), followed by APC-conjugated Anti-Mouse IgG Secondary Antibody (Catalog # F0101B). View our protocol for Staining Membrane-associated Proteins.Aminopeptidase N/CD13 in Human Liver.
Aminopeptidase N/CD13 was detected in immersion fixed paraffin-embedded sections of human liver using Mouse Anti-Human Aminopeptidase N/CD13 Monoclonal Antibody (Catalog # MAB38152) at 0.5 µg/mL for 1 hour at room temperature followed by incubation with the Anti-Mouse IgG VisUCyte™ HRP Polymer Antibody (Catalog # VC001). Before incubation with the primary antibody, tissue was subjected to heat-induced epitope retrieval using Antigen Retrieval Reagent-Basic (Catalog # CTS013). Tissue was stained using DAB (brown) and counterstained with hematoxylin (blue). Specific staining was localized to bile canaliculi. View our protocol for IHC Staining with VisUCyte HRP Polymer Detection Reagents.Aminopeptidase N/CD13 in Human Kidney.
Aminopeptidase N/CD13 was detected in immersion fixed paraffin-embedded sections of human kidney using Mouse Anti-Human Aminopeptidase N/CD13 Monoclonal Antibody (Catalog # MAB38152) at 0.5 µg/mL for 1 hour at room temperature followed by incubation with the Anti-Mouse IgG VisUCyte™ HRP Polymer Antibody (Catalog # VC001). Before incubation with the primary antibody, tissue was subjected to heat-induced epitope retrieval using Antigen Retrieval Reagent-Basic (Catalog # CTS013). Tissue was stained using DAB (brown) and counterstained with hematoxylin (blue). Specific staining was localized to cytoplasm in convoluted tubules. View our protocol for IHC Staining with VisUCyte HRP Polymer Detection Reagents.Applications for Human Aminopeptidase N/CD13 Antibody
CyTOF-ready
Flow Cytometry
Sample: U937 Human cell line
Immunohistochemistry
Sample: Immersion fixed paraffin-embedded sections of human liver and human kidney
Formulation, Preparation, and Storage
Purification
Reconstitution
Formulation
Shipping
Stability & Storage
- 12 months from date of receipt, -20 to -70 °C as supplied.
- 1 month, 2 to 8 °C under sterile conditions after reconstitution.
- 6 months, -20 to -70 °C under sterile conditions after reconstitution.
Background: Aminopeptidase N/CD13
The human ANPEP gene encodes aminopeptidase N (APN), which is also known as microsomal aminopeptidase, alanyl aminopeptidase, aminopeptidase M, CD13, or membrane protein p161 (1‑3). The deduced amino acid sequence of human APN consists of a short cytoplasmic tail (residues 2 to 8), a transmembrane region (residue 9 to 32), a Ser/Thr rich region and a zinc metalloprotease domain (residues 69 to 966). The amino acid sequence of human APN is 78% and 77% identical to that of rat and mouse, respectively. Widely expressed in many cells, tissues and species, APN cleaves the N-terminal amino acids from bioactive peptides, leading to their inactivation or degradation. The roles of APN in many fields, such as neuroscience, hematopoeitic cells, immune system, angiogenesis, cancer and viral infection, have been reviewed (3).
References
- Olsen, J. et al. (1988) FEBS Lett. 238:307.
- Look, A.T. et al. (1989) J. Clin. Invest. 83:1299.
- Turner, A.J. (2004) in Handbook of Proteolytic Enzymes (ed. Barrett, et al.) pp. 289, Academic Press, San Diego.
Alternate Names
Gene Symbol
UniProt
Additional Aminopeptidase N/CD13 Products
Product Documents for Human Aminopeptidase N/CD13 Antibody
Product Specific Notices for Human Aminopeptidase N/CD13 Antibody
For research use only